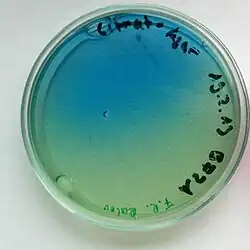

Raoultella planticola
| Raoultella planticola | |
|---|---|
| |
| Scientific classification | |
| Domain: | Bacteria |
| Kingdom: | Pseudomonadati |
| Phylum: | Pseudomonadota |
| Class: | Gammaproteobacteria |
| Order: | Enterobacterales |
| Family: | Enterobacteriaceae |
| Genus: | Raoultella |
| Species: | R. planticola |
| Binomial name | |
| Raoultella planticola Bagley et al. 1982[1] | |
| Synonyms | |
|
Klebsiella planticola,[2][3][4][5][6][7][8] Klebsiella trevisanii[9] | |

Raoultella planticola is a species of Gram-negative[10] bacteria in the genus Raoultella.[5][11][12][13][14][15][16] R. planticola is quite similar in appearance to Klebsiella pneumoniae and must be identified based on growth habits or DNA analysis. A number of strains have been identified.[17][18]
Human infection
Infections are rare, and mostly seen in immunocompromised patients.[19][20][21] R. planticola has been determined to have complicated at least one case of severe pancreatitis.[22]
Strains
A strain of Raoultella planticola, Cd-1 has been found which grows anaerobically at high aqueous cadmium concentrations and precipitates insoluble cadmium sulfide. This strain has been isolated from reducing salt marsh sediments and may be useful in bioremediation of cadmium from exposed soils.[23]
Taxonomic reclassification
Raoultella planticola was formerly classified as part of the genus Klebsiella. It was reclassified along with several other Klebsiella species in 2001.[24]
Genetic modification
In the late 1980s R. planticola was genetically modified by inserting a plasmid from Zymomonas mobilis. This plasmid codes for the enzyme pyruvate decarboxylase which, along with alcohol dehydrogenase already present in the bacteria allow it to produce ethanol. The bacteria already does produce ethanol when metabolizing hexoses and pentoses, but very inefficiently. R. planticola was chosen to receive this gene as it already had metabolic pathways to breakdown pentose sugars such as xylose, which is a main component of agricultural and forest residues.[25][26] The results showed that the genetically modified strain could produce ethanol but were killed at concentrations of ethanol greater than 5%. The modified strain also produced more ethanol at lower pH (5.4) and ethanol production decreased as pH increased.[25]
In the early 1990s, a biotech company set out to solve a problem: how to destroy crop residue safely. Some crops' residues harbor plant pathogens. Burning is occasionally used to destroy the residue and pathogens, but this is a fire hazard and can be dangerous for the environment. This company realized that, because R. planticola is an aggressive and abundant soil bacterium, it could be genetically modified to destroy crop residue and also create ethanol.
Testing of this process was originally limited to sterile soil. Ph.D. research conducted at Oregon State University, supervised by Elaine Ingham, obtained a sample of the genetically modified organism for assessing ecological effects through the German Institut für Biotechnologie and, testing it in non-sterile (ordinary) soil, found that the modified bacteria caused small amounts of alcohol in the soil.[27][28][29] While this level is several hundred times lower than required to affect plant growth, this fact combined with the fact that R. planticola is already found growing in the root systems of all kinds of plants everywhere, sparked a doomsday myth.[30][28]
Fallacy of GMO claims
Dr Ingham claimed to a New Zealand Commission that "the likely effect of allowing the field trial [with the genetically modified bacteria in question] would have been to destroy terrestrial plants".[30][28][31] Ingham's suggestion of a possibility of "worldwide plant death" attracted attention from the scientific community. However, they were unable to find any evidence that these claims had been submitted to scientific publication in a peer-reviewed journal, and no evidence was found to indicate the U.S. EPA or U.S. Dept. of Agriculture had reviewed or approved any trials for SDF20.[31][32] Additionally, the SDF20 was found to have produced 20 micrograms per milliliter of alcohol in the soil which is several hundred times lower than that required to affect plant growth.[33][32]
Elaine Ingham has issued a public apology for submitting false claims about ecological impact of GMOs.[34]
The Green Party of New Zealand has issued a public apology for misleading statements and acknowledging that a cited research was never published.[35]
In the episode "The Pyramid at the End of the World" of the BBC television show Doctor Who, the Doctor stops a genetically modified strain of R. planticola from causing a worldwide plant and animal die-off similar to the scenario that some scientists have speculated about.
References
- ↑ Namebank Record Detail. Ubio.org (2003-04-28). Retrieved on 2011-10-21.
- ↑ Namebank Record Detail. Ubio.org (2005-09-22). Retrieved on 2011-10-21.
- ↑ Taxonomy browser (Raoultella planticola). Ncbi.nlm.nih.gov. Retrieved on 2011-10-21.
- ↑ Klebsiella cf. planticola B43 - Encyclopedia of Life. EOL (2011-09-28). Retrieved on 2011-10-21.
- 1 2 "2010 Annual Checklist :: Species details". Catalogue of Life. Retrieved 2012-05-07.
- ↑ Namebank Record Detail. Ubio.org (2003-04-28). Retrieved on 2011-10-21.
- ↑ Data Use Agreement - GBIF Portal. Data.gbif.org (2007-02-22). Retrieved on 2011-10-21.
- ↑ Data Use Agreement - GBIF Portal. Data.gbif.org (2007-02-22). Retrieved on 2011-10-21.
- ↑ Raoultella planticola. Thelabrat.com. Retrieved on 2011-10-21.
- ↑ Bagley, Susan T.; Seidler, Ramon J.; Brenner, Don J. (March 1981). "Klebsiella planticola sp. nov.: A new species of enterobacteriaceae found primarily in nonclinical environments". Current Microbiology. 6 (2): 105–109. doi:10.1007/BF01569013. S2CID 19935030.
- ↑ Raoultella planticola. Zipcodezoo.com (2009-04-06). Retrieved on 2011-10-21.
- ↑ Data Use Agreement - GBIF Portal. Data.gbif.org (2007-02-22). Retrieved on 2011-10-21.
- ↑ Data Use Agreement - GBIF Portal. Data.gbif.org (2007-02-22). Retrieved on 2011-10-21.
- ↑ Namebank Record Detail. Ubio.org (2005-09-22). Retrieved on 2011-10-21.
- ↑ NLBIF : Raoultella planticola (Bagley et al. 1982) Drancourt et al. 2001. Nlbif.nl. Retrieved on 2011-10-21.
- ↑ Raoultella planticola - Encyclopedia of Life. EOL. Retrieved on 2011-10-21.
- ↑ Raoultella planticola (Klebsiella planticola). Uniprot.org. Retrieved on 2011-10-21.
- ↑ Raoultella planticola Taxon Passport Archived 2011-07-22 at the Wayback Machine. StrainInfo. Retrieved on 2011-10-21.
- ↑ Westerveld, D.; Hussain, J.; Aljaafareh, A.; Ataya, A. (2017). "A Rare Case of Raoultella planticola Pneumonia: An Emerging Pathogen". Respiratory Medicine Case Reports. 21: 69–70. doi:10.1016/j.rmcr.2017.03.018. PMC 5382143. PMID 28409111.
- ↑ Huynh, Jessica; Fleet, Jamie; Peng, Jonathan; La, Julie; Wyne, Ahraaz (2018-09-06). "A clinical vignette on Raoultella planticola bacteremia". Journal of the Association of Medical Microbiology and Infectious Disease Canada. 3 (3): 137–140. doi:10.3138/jammi.2017-0005. ISSN 2371-0888.
- ↑ Povlow, Michael R; Carrizosa, Jaime; Jones, Adriana (2017-07-24). "Raoultella Planticola: Bacteremia and Sepsis in a Patient with Cirrhosis". Cureus. 9 (7) e1508. doi:10.7759/cureus.1508. ISSN 2168-8184. PMC 5608487. PMID 28948128.
- ↑ Alves MS, Riley LW, Moreira BM (May 2007). "A case of severe pancreatitis complicated by Raoultella planticola infection". J. Med. Microbiol. 56 (Pt 5): 696–8. doi:10.1099/jmm.0.46889-0. PMID 17446297.
- ↑ Sharma, P. K.; Balkwill, D. L.; Frenkel, A.; Vairavamurthy, M. A. (1 July 2000). "A New Klebsiella planticola Strain (Cd-1) Grows Anaerobically at High Cadmium Concentrations and Precipitates Cadmium Sulfide". Applied and Environmental Microbiology. 66 (7): 3083–3087. Bibcode:2000ApEnM..66.3083S. doi:10.1128/AEM.66.7.3083-3087.2000. PMC 92115. PMID 10877810.
- ↑ Drancourt, M; Bollet, C; Carta, A; Rousselier, P (2001). "Phylogenetic analyses of Klebsiella species delineate Klebsiella And raoultella gen. nov., with description of Raoultella ornithinolytica comb. Nov., Raoultella terrigena comb. Nov. And Raoultella planticola comb. Nov". International Journal of Systematic and Evolutionary Microbiology. 51 (Pt 3): 925–32. doi:10.1099/00207713-51-3-925. PMID 11411716.
- 1 2 Tolan, JS; Finn, RK (September 1987). "Fermentation of d-Xylose to Ethanol by Genetically Modified Klebsiella planticola". Applied and Environmental Microbiology. 53 (9): 2039–44. Bibcode:1987ApEnM..53.2039T. doi:10.1128/AEM.53.9.2039-2044.1987. PMC 204054. PMID 16347427.
- ↑ Feldmann, Sigrun; Sprenger, Georg A.; Sahm, Hermann (August 1989). "Ethanol production from xylose with a pyruvate-formate-lyase mutant of Klebsiella planticola carrying a pyruvate-decarboxylase gene from Zymomonas mobilis". Applied Microbiology and Biotechnology. 31 (2): 152–157. doi:10.1007/BF00262454. S2CID 29865373.
- ↑ Holmes, Michael T (1995). Ecological assessment after the addition of genetically engineered Klebsiella planticola SDF20 into soil (Ph.D.). Oregon State University. hdl:1957/34510.
- 1 2 3 Elaine Ingham (Winter 1999). "Good Intentions and Engineering Organisms that Kill Wheat". Synthesis/Regeneration. No. 18. Archived from the original on 2016-04-23. Retrieved 2015-11-24.
- ↑ Holmes, M. T.; Ingham, E. R.; Doyle, J. D.; Hendricks, C. W. (1999-01-03). "Effects of Klebsiella planticola SDF20 on soil biota and wheat growth in sandy soil". Applied Soil Ecology. 11 (1): 67–78. Bibcode:1999AppSE..11...67H. doi:10.1016/S0929-1393(98)00129-2.
- 1 2 "Klebsiella planticola—The Gene-Altered Monster That Almost Got Away". San Francisco State University. Retrieved 2015-11-24.
- 1 2 Fletcher, Liz (2001). "New Zealand GMO debacle undermines green lobby". Nature Biotechnology. 19 (4): 292. doi:10.1038/86618. PMID 11283556. S2CID 33027459.
- 1 2 "Evidence in Rebuttal - Life Sciences Network". Retrieved February 5, 2021.
- ↑ Porterfield, Andrew (2016-09-06). "Did you hear about the GMO that almost destroyed all life?". geneticliteracyproject.org. Genetic Literacy Project. Retrieved 6 September 2016.
- ↑ Fletcher, Liz (2001). "New Zealand GMO debacle undermines green lobby". Nature Biotechnology. 19 (4). Nature: 292. doi:10.1038/86618. PMID 11283556. S2CID 33027459.
- ↑ Aotearoa, Green Party of. "Amendment to evidence presented to the Royal Commission of Inquiry into Genetic Modification". gene.ch. Retrieved 6 October 2016.
Further reading
- Westbrook GL, O'Hara CM, Roman SB, Miller JM (April 2000). "Incidence and identification of Klebsiella planticola in clinical isolates with emphasis on newborns". J. Clin. Microbiol. 38 (4): 1495–7. doi:10.1128/JCM.38.4.1495-1497.2000. PMC 86473. PMID 10747132.
- Podschun R, Acktun H, Okpara J, Linderkamp O, Ullmann U, Borneff-Lipp M (August 1998). "Isolation of Klebsiella planticola from newborns in a neonatal ward". J. Clin. Microbiol. 36 (8): 2331–2. doi:10.1128/JCM.36.8.2331-2332.1998. PMC 105041. PMID 9666015.
- Klebsiella planticola
- Monnet D, Freney J (April 1994). "Method for differentiating Klebsiella planticola and Klebsiella terrigena from other Klebsiella species". J. Clin. Microbiol. 32 (4): 1121–2. doi:10.1128/JCM.32.4.1121-1122.1994. PMC 267203. PMID 8027329.
- Kanki M, Yoda T, Tsukamoto T, Shibata T (July 2002). "Klebsiella pneumoniae produces no histamine: Raoultella planticola and Raoultella ornithinolytica strains are histamine producers". Appl. Environ. Microbiol. 68 (7): 3462–6. Bibcode:2002ApEnM..68.3462K. doi:10.1128/AEM.68.7.3462-3466.2002. PMC 126807. PMID 12089029.